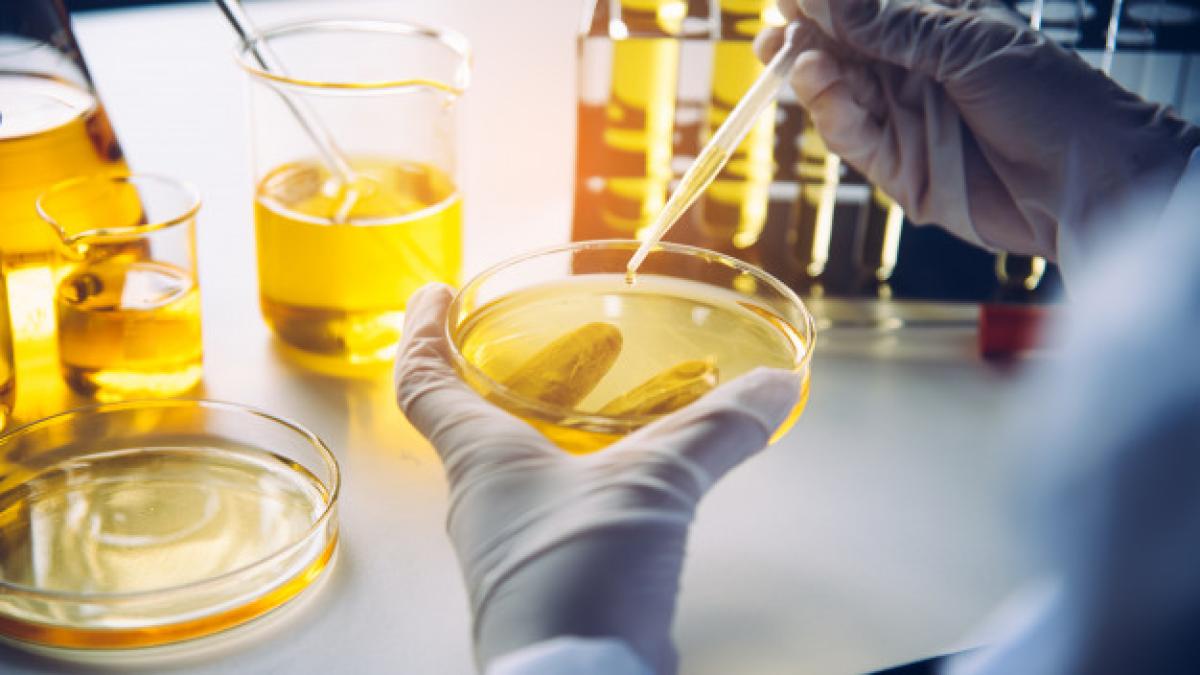
lab_94877500

Cercetările întreprinse de specialiștii chinezi au arătat că SARS-CoV-2 rămâne virulent, adică își păstrează capacitatea de a provoca boala covid-19, timp de două zile pe suprafața unui somon ținut la o temperatură de 25 de grade Celsius și până la opt zile, cel puțin la o temperatură de numai 4 grade deasupra lui 0.
În lucrarea lor, experții chinezi atrag atenția că, în piețe, restaurante sau în containerele de transport, peștele este păstrat la o temperatură de 4 grade Celsius. Iar uneori, un somon de calitate pescuit din anumite mări și cerut în întreaga lume, poate călători zile întregi înainte să ajungă la destinație.
”Peștele de import sau export se păstrează, conform normelor, la temperatură care nu trebuie să depășească 4 grade. În aceste condiții, somonul contaminat cu SARS-CoV-2 se transportă dintr-o țară în alta în decursul unei săptămâni, devenind, astfel, una dintre sursele răspândirii internaționale a noului coronavirus”, se arată în textul studiului menționat mai sus.
Citește și Vaccinul anti-covid al rușilor. Informații INCREDIBILE din culise
Spre deosebire de legume și fructe, peștele trebuie transportat în condiții stricte de temperatură și umiditate, ceea ce înseamnă că virusul de pe suprafața peștelui vândut în piețele și magazinele specializate poate supraviețui o perioadă lungă de timp.